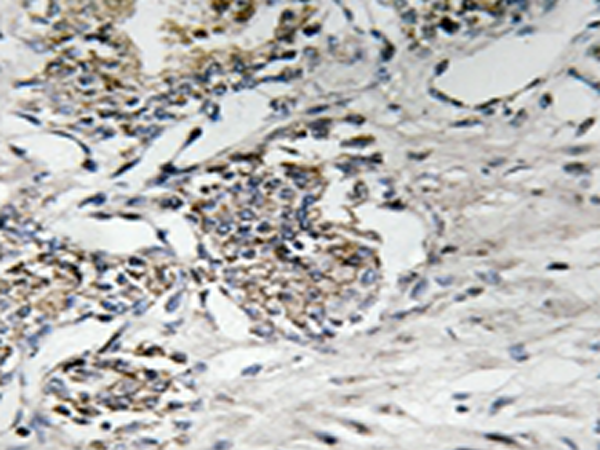

中文名稱:兔抗CLDN7(Ab-210) 多克隆抗體
英文名稱:Anti-CLDN7(Ab-210) rabbit polyclonal antibody
|
Background: |
Plays a major role in tight junction-specific obliteration of the intercellular space By similarity. |
|
Applications: |
WB, IHC |
|
Name of antibody: |
CLDN7(Ab-210) |
|
Immunogen: |
Synthesized non-phosphopeptide derived from human Claudin 7 around the phosphorylation site of tyrosine 210 (S-K-E-Y(p)-V). |
|
Full name: |
claudin 7 |
|
Synonyms: |
CLDN-7; CEPTRL2; CPETRL2; Hs.84359; claudin- |
|
SwissProt: |
O95471 |
|
IHC positive control: |
Human prostate carcinoma tissue |
|
IHC Recommend dilution: |
50-100 |
|
WB Predicted band size: |
22 kDa |
|
WB Positive control: |
Rat liver tissue lysate |
|
WB Recommended dilution: |
500-3000 |
購(gòu)物車
幫助
021-54845833/15800441009
